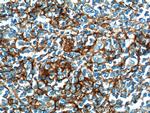
CD23 Antibody in Immunohistochemistry (Paraffin) (IHC (P))

Search
Proteintech
CD23 Polyclonal Antibody
{{$productOrderCtrl.translations['antibody.pdp.commerceCard.promotion.promotions']}}
{{$productOrderCtrl.translations['antibody.pdp.commerceCard.promotion.viewpromo']}}
{{$productOrderCtrl.translations['antibody.pdp.commerceCard.promotion.promocode']}}: {{promo.promoCode}} {{promo.promoTitle}} {{promo.promoDescription}}. {{$productOrderCtrl.translations['antibody.pdp.commerceCard.promotion.learnmore']}}
产品信息
18642-1-AP
种属反应
宿主/亚型
分类
类型
抗原
偶联物
形式
浓度
规格
纯化类型
保存液
内含物
保存条件
运输条件
产品详细信息
Immunogen sequence: MEEGQYSEI EELPRRRCCR RGTQIVLLGL VTAALWAGLL TLLLLWHWDT TQSLKQLEER AARNVSQVSK NLESHHGDQM AQKSQSTQIS QELEELRAEQ QRLKSQDLEL SWNLNGLQAD LSSFKSQELN ERNEASDLLE RLREEVTKLR MELQVSSGFV CNTCPEKWIN FQRKCYYFGK GTKQWVHARY ACDDMEGQLV SIHSPEEQDF LTKHASHTGS WIGLRNLDLK GEFIWVDGSH VDYSNWAPGE PTSRSQGEDC VMMRGSGRWN DAFCDRKLGA WVCDRLATCT PPASEGSAES MGPDSRPDPD GRLPTPSAPL HS (1-321 aa encoded by BC014108)
靶标信息
CD23 is a 45 kDa glycoprotein that serves as a low-affinity receptor for IgE, playing a crucial role in regulating IgE responses and B cell activation. It is expressed on mature B cells, mantle zone B cells, follicular dendritic cells, and at lower levels on T cells, NK cells, Langerhans cells, and platelets. CD23 expression is upregulated upon B cell activation, and its soluble forms are biologically active, acting as potent mitogenic factors. CD23 is strongly expressed on Epstein-Barr virus (EBV)-transformed B lymphoblasts and is present on a subpopulation of freshly isolated peripheral blood and tonsil B cells. It is also detected in neoplastic cells from cases of B cell chronic lymphocytic leukemia and some centroblastic/centrocytic lymphomas. Functionally, CD23 is involved in B cell growth, differentiation, and IgE production. It interacts with CD21 and the alpha subunits of CD11b and CD11c, further influencing immune responses. Diseases associated with CD23 dysfunction include chronic conjunctivitis and chronic lymphocytic leukemia, highlighting its importance in both normal immune function and disease states. This makes CD23 a valuable target for antibody customers interested in B-cell-related research and diagnostics.
仅用于科研。不用于诊断过程。未经明确授权不得转售。
篇参考文献 (0)
生物信息学
蛋白别名: BLAST-2; C-type lectin domain family 4 member J; C-type lectin domain family 4, member J; CD23; CD23 antigen; Fc fragment of IgE receptor II; Fc fragment of IgE, low affinity II, receptor for (CD23); Fc-epsilon receptor old gene name 'FCE1A'; Fc-epsilon-RII; FcepsilonRII; FceRII; Immunoglobulin E-binding factor; immunoglobulin epsilon-chain; Low affinity immunoglobulin epsilon Fc receptor; Lymphocyte IgE receptor; unnamed protein product
基因别名: BLAST-2; CD23; CD23A; CLEC4J; FCE2; FCER2; FCErII; IGEBF
UniProt ID: (Human) P06734
Entrez Gene ID: (Human) 2208